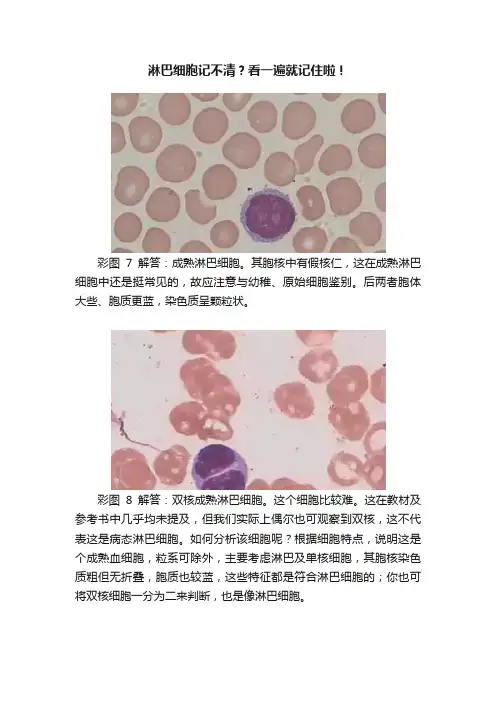

成熟淋巴细胞形态特点
- 格式:docx
- 大小:36.54 KB
- 文档页数:1

淋巴细胞的形状和大小如何?一、淋巴细胞的主要形态淋巴细胞是一类核细胞,其主要形态特征表现为细小的圆形或近似圆形形态。
在显微镜下观察,可以看到淋巴细胞的胞质呈浅蓝色,核周围含有一圈较宽的淡色胞浆,核质比例较小。
整体上,淋巴细胞形状规则,胞质丰满,呈现出干净、整齐的特点。
这种形态特征,使得淋巴细胞在免疫系统中发挥着重要的作用。
二、淋巴细胞的大小范围1. 外周血淋巴细胞:根据研究结果显示,外周血淋巴细胞的直径一般在8-15微米之间,平均直径约为10微米左右。
值得注意的是,成熟淋巴细胞的大小在个体间存在一定的变异性,但总体范围在上述区间内。
2. 淋巴结淋巴细胞:淋巴结是免疫系统中一个重要的器官,其中存在大量的淋巴细胞。
由于淋巴结淋巴细胞类型多样,其大小也存在一定的差异。
一般而言,淋巴结淋巴细胞的直径较外周血淋巴细胞稍大,大致在10-20微米之间。
三、淋巴细胞形状的变异性1. 非活化淋巴细胞:在非活化状态下,淋巴细胞形态呈规则圆形或近似圆形,细胞膜清晰,胞质均匀一致。
这是淋巴细胞的一种典型形态,也是一种功能性不活跃状态的体现。
2. 活化淋巴细胞:当淋巴细胞被激活后,其形态会发生一定的变化。
激活淋巴细胞的形态特征包括突起或伸出的细胞突,胞质内的颗粒增多,在显微镜下观察呈现出星状或分叶状的形态。
活化状态的淋巴细胞具有更强的免疫功能,能更好地应对感染和疾病的挑战。
四、淋巴细胞形态与功能的关系淋巴细胞的形态特征与其功能密切相关。
形态规则、干净整齐的淋巴细胞在免疫系统中扮演着监测和调节的角色,维持机体的内稳态。
而活化状态下的淋巴细胞则能够迅速应对外界刺激,参与免疫应答过程,调节免疫反应的强度和方向。
总结:淋巴细胞的形状主要呈现出细小的圆形或近似圆形,并具有规则、干净、整齐的特点。
在免疫功能方面,形态规则的淋巴细胞主要参与监测和调控机体内稳态,而活化状态下的淋巴细胞能够迅速应对外界刺激,参与免疫应答过程。
对于淋巴细胞的形态和大小的认识,有助于增强我们对于免疫系统的认识,深化对于免疫功能的理解。


临床血液学红细胞系统、粒细胞系统、巨核细胞系统、单核细胞系统、组织细胞系统、淋巴细胞系统、浆细胞系统等细胞特点和常细胞疾病提示及识别方法与要点血细胞的命名:命名六系三过程,粒红巨单浆和淋;原始幼稚与成熟,早幼中幼晚幼型。
血细胞成熟规律:成熟规律有共性,由大到小是特征;质细到粗疏变密,仁有到无粒体生。
红细胞系统1、原红细胞:原红圆或椭圆形,色染深蓝不透明;浆有瘤状小突起,核大居中有核仁。
2、副原红细胞:副原红见红血病,浆核紊乱异步行;核熟要比胞浆早,浆含空泡核畸形。
3、早幼红细胞:早幼红属嗜碱性,浆多色蓝稍透明;核仁模糊或消失,质变粗密核居心。
4、中幼红细胞:中幼红呈多色性,核渐缩小无核仁;浆色灰蓝转灰红,质似碎墨龟背形。
5、晚幼红细胞:晚幼红小更好认,两大特点要记清;核质集聚如炭核,去核便是成熟型。
6、巨幼红细胞:巨幼红大是特征,原早中晚呈巨型;浆多丰满核晚熟,巨幼贫血常增生。
7、小幼红细胞:小幼红称侏儒型,老核幼浆是特征;核圆或呈梅花状,缺铁贫血所造成。
8、网织红细胞:网织红属过渡型,浆含线粒嗜碱性;活体染色呈网状,通常将它分五型。
9、成熟红细胞:成熟红为正常型,中凹边厚似圆饼;无核浆呈淡红色,周围略比中央深。
10、小红细胞:小红体小见增贫,合成障碍所造成;缺铁贫血常出现,或见血红蛋白病。
11、大红细胞:大红体大见溶贫,或见巨幼贫血人;胞体常比正常大,提前脱核所形成。
12、巨红细胞:巨红巨大是特征,巨幼脱核所形成;中央淡染不明显,恶性贫血常增生13、超巨红细胞:超巨红呈超巨型,病态造血所造成;红白血病常出现,抗癌化疗也增生。
14、红细胞大小不均:大小不均见增贫,巨幼贫血也增生;直径相差一倍多,粗制滥造所形成。
15、红细胞形态不整:形态不整称异形,常见骨纤和增贫;如梨似拍呈棒状,或呈纺缍和哑铃。
16、球形红细胞:球形红小圆球形,淡染消失厚度增;色深体比正常小,常见遗传和溶贫。
17、椭圆形红细胞:椭红遗传所造成,偶见缺铁和巨贫;胞体较长呈桶状,长径三倍于横径。

淋巴细胞记不清?看一遍就记住啦!彩图7解答:成熟淋巴细胞。
其胞核中有假核仁,这在成熟淋巴细胞中还是挺常见的,故应注意与幼稚、原始细胞鉴别。
后两者胞体大些、胞质更蓝,染色质呈颗粒状。
彩图8解答:双核成熟淋巴细胞。
这个细胞比较难。
这在教材及参考书中几乎均未提及,但我们实际上偶尔也可观察到双核,这不代表这是病态淋巴细胞。
如何分析该细胞呢?根据细胞特点,说明这是个成熟血细胞,粒系可除外,主要考虑淋巴及单核细胞,其胞核染色质粗但无折叠,胞质也较蓝,这些特征都是符合淋巴细胞的;你也可将双核细胞一分为二来判断,也是像淋巴细胞。
彩图11解答:涂抹细胞(下)及成熟淋巴细胞(上)。
该淋巴细胞核中有假核仁(如果是真核仁其周围染色质应呈颗粒状),胞质呈清澈的淡蓝色(这也是成熟细胞的特征之一)。
彩图21解答:淋巴细胞。
血片中的成熟淋巴细胞形态也是各种各样的,其胞体也可呈条带状。
彩图25解答:(大)淋巴细胞。
其胞体较大,胞质较多,清澈淡蓝色,并有少许紫红色颗粒,胞核肾形,染色质较粗(但副染色质不明显,这是多数成熟淋巴细胞的特点)。
该细胞的形态是有点似晚幼粒,但其胞质中无中性颗粒,这是两者最主要的鉴别点。
彩图29解答:成熟淋巴细胞。
血片中偶尔可见淋巴细胞胞质毛状突起,这是正常的,所以平时偶尔看到这样的细胞应归入正常淋巴细胞而不称为毛细胞。
在毛细胞白血病中,可见大量类似的细胞(即为毛细胞)。
小巨核是种成熟巨核细胞,其胞质中应含有许多颗粒,而原巨大些、染色质也细,故均不像。
彩图42解答:两个淋巴细胞。
左边似乎受周围细胞挤压而变形。
这两个细胞胞体不大、胞质不多也不深蓝,所以不是异淋哦,要抓住异淋的一些主要特征哦。
彩图47解答:淋巴细胞。
很多人可能会认为是单核细胞,可能觉得核杆状又无中性颗粒,其实淋巴细胞的核也可各种各样。
仔细观察该细胞,其胞体不是很大,胞质为较清澈的淡蓝色,核染色质致密。
胞核虽然呈杆状,但其核结构及胞质的特点均不像中性杆状核粒细胞。


白细胞形态与分类计数检查:(人医实验诊断学书)1.中性粒细胞(1)正常形态:中性粒细胞在外周血中可分为中性杆状核粒细胞(直径为10-13um)和中性分叶核粒细胞两类(核紫色)。
细胞体呈圆形,胞质丰富,染粉红色,含较多细小均匀的淡粉红色中性颗粒。
胞核染为深紫红色,染色质紧密成块状,核形弯曲呈杆状的称杆状核,有时核弯曲盘绕而呈C形、S形、V形或不规则形,而核呈分叶核的称为分叶核,通常为2-5叶,叶与叶之间以细丝相连,一般以2-3叶居多,病理情况下,分叶可达10叶。
分叶少者属幼稚细胞,分叶越多表示越成熟或越衰老。
(2)中性粒细胞形态异常1.中性粒细胞的中毒性改变:大小不均、中毒颗粒、空泡形成、杜勒小体(胞质里的嗜碱区域)、核变性(核固缩、溶解、碎裂)2.分叶过多:这种细胞核分叶过多,常超过5叶以上、甚至在10叶以上、核染色质疏松、多见于巨幼细胞贫血或应用抗代谢药物治疗后。
3.与遗传有关的异常形态变化(3)中性粒细胞的核象变化:在正常人周围血液的中性粒细胞中,具有分叶核的占绝大多数(50%-70%)以2~3叶最多,而不分叶(杆状核粒细胞占1-5%)或分叶过多的较少。
在病理情况下,中性粒细胞核象可发生变化,出现核左移或核右移现象。
核左移——外周血中出现不分叶核粒细胞(包括杆状核粒细胞、晚幼粒细胞、中幼粒细胞或早幼粒细胞等)的百分率增高(超过5%)时,称核左移。
核轻度左移伴白细胞总数及中性粒细胞百分率增高者,表示感染轻,机体抵抗力强。
核明显左移伴白细胞总数及中性粒细胞增多者,表示感染严重。
核显著左移但白细胞总数不增高或减低者者,表示感染极度严重。
核右移——正常人外周血中的中性粒细胞以3叶核者为主,若中性粒细胞核5叶以上者百分率超过3%者,称为核右移。
此时常伴白细胞总数减少。
在炎症恢复期,一过性出现核右移是正常现象,如在疾病进展期,突然出现核右移的变化,则表示预后不良。
2.嗜酸性粒细胞形态:胞体呈圆形,直径为13~15um。



临床基础检验学技术一.大题:⒈中性粒细胞临床意义(病理性)⒉淋巴细胞的异常形态⑴异型淋巴细胞:在病毒性感染(传染性单核细胞增多症、病毒性肝炎、肺炎、传染性淋巴细胞增多症等)或者过敏性疾病中,可使淋巴细胞增生,并产生形态变化。
I型:空泡型或者浆细胞型,常见类似淋巴细胞大小,胞质丰富,嗜碱性深蓝色,有大小不等空泡,无颗粒,核偏位,略固缩。
II型:不规则型,单核细胞型,胞体较大,外形不规则,呈花边状,似单核细胞,胞质量多,呈浅蓝或者蓝色,无空泡,可有少量天青颗粒,胞核圆形或者不规则,染色质疏松。
III型:幼稚型,未成熟型,胞体较大,胞质量多,呈蓝或者深蓝色,偶有空泡,无颗粒,胞核大较规则,染色质细致均匀异形淋巴细胞增多主要见于传染性单核细胞增多症、病毒性肝炎、流行性出血热、湿疹等毒性疾病和过敏性疾病。
⑵褪变型淋巴细胞:大剂量放射线照射后,淋巴细胞减少,且出现核固缩、核破碎、双核、卫星核等变化3.管型形成的必要条件①蛋白尿的存在(原尿中的白蛋白和肾小管分泌的T-H蛋白)②肾小管有使尿液浓缩酸化的能力,同时尿流缓慢及局部性尿液积滞,肾单位中形成的管型在重新排尿时随尿排出③具有可供交替使用的肾单位。
因尿液通过炎症损伤部位时,有白细胞、红细胞、上皮细胞等脱落粘附在处于凝结过程的蛋白质之中而形成细胞管型。
如附着的细胞退化变性,崩解成细胞碎屑,则形成粗或细颗粒管型。
在急性血管内溶血时由于大量游离血红蛋白从肾小球滤过肾小管内形成血红蛋白管型。
如肾小管上皮细胞出现脂肪变性,形成脂肪管型,进一步变性可形成蜡样管型。
根据管型内含物的不同可分为透明、颗粒、细胞(红细胞、白细胞、上皮细胞)、血红蛋白、脂肪、蜡样等管型。
还应注意细菌、真菌、结晶体及血小板等特殊管型。
尿液尿沉渣计数和显微镜检验4.粪便隐血试验临床意义⑴消化道出血的重要指标之一⑵消化道溃疡的疗效判断⑶作为消化道恶性肿瘤普查的一个筛选指标消化性溃疡所至出血→多呈间断性阳性消化道恶性肿瘤→多为持续性阳性5.标本采集和处理的注意事项★★6.光学显微镜的维护1.注意电源工作电压的波动范围(<10%),电源开关不要短时频繁开关,显微镜使用间隙注意调低照明亮度。
斑马鱼外周血液及造血器官血细胞发生的观察曹文芝;刘云;梁冰;姜国良;韩茵【摘要】通过对斑马鱼外周血涂片以及肝脏、肾脏和脾脏的组织印迹片进行Wright's Giemsa混合染色,光镜观察其中各种血细胞的大小、形态特征,并对血细胞进行分类统计,研究了斑马鱼外周及造血组织血细胞的发生过程.研究发现,斑马鱼的血细胞除红细胞外,还包括单核细胞、淋巴细胞、嗜中性粒细胞、少量的嗜酸性粒细胞、嗜碱性粒细胞和血栓细胞.斑马鱼血细胞的发育大致经过3个阶段,即原始阶段、幼稚阶段和成熟阶段.造血母细胞从造血器官释放入外周血中有一个成熟过程.原始红细胞只在肾脏中出现,而肾脏中幼稚型红细胞的数目也最多.原始粒细胞、原单核细胞和原淋巴细胞在3种器官中均有出现,肾脏最多.可见肾脏是斑马鱼主要造血器官,脾脏和肝脏是其辅助造血器官.【期刊名称】《水产科学》【年(卷),期】2014(033)007【总页数】7页(P403-409)【关键词】斑马鱼;血细胞;血细胞发生;造血器官【作者】曹文芝;刘云;梁冰;姜国良;韩茵【作者单位】中国海洋大学海洋生命学院,山东青岛266003;中国海洋大学海洋生命学院,山东青岛266003;中国海洋大学海洋生命学院,山东青岛266003;中国海洋大学海洋生命学院,山东青岛266003;中国海洋大学海洋生命学院,山东青岛266003【正文语种】中文【中图分类】Q959.468动物体的血细胞对自身生理状态变化和外界环境因子的刺激非常敏感,是机体免疫的重要成分[1]。
由于鱼类缺乏完善的淋巴系统,因此血液免疫是鱼类的重要免疫机制。
鱼类的血细胞不仅具有运输、体液调节、吞噬、分泌等功能,还能参与机体损伤修复、免疫防御等生理机能,从而维持各种生理环境的相对稳定。
虽然目前关于鱼类血细胞的研究已有一些报道,但我们发现,因为鱼类种属、品系、生长环境等的差异,血细胞在形态、结构、起源、功能等方面也会表现出差异。
开展鱼类血液学的研究,在鱼类的演化、分类、病理学、免疫学、环境监测等领域都有重要的意义。
成熟淋巴细胞形态特点
成熟淋巴细胞是一种具有免疫功能的细胞,存在于人体的淋巴组织中。
成熟淋巴细胞的形态特点可以通过镜下观察来确定。
在淋巴细胞的形态中,核是最明显的特点。
成熟淋巴细胞的核一般为圆形或卵圆形,核质比较深染,大小较大。
细胞核内可以发现一些特殊的结构物质,称为染色质,染色质会影响到淋巴细胞的形态和功能。
另外,成熟淋巴细胞的胞质体积相对较大,胞质中含有一些有机物质,如线粒体、内质网等。
这些物质对于淋巴细胞的代谢活动有着十分重要的作用。
在淋巴细胞形态方面,还存在一些区别于其他细胞的特征。
成熟淋巴细胞的表面有一些可识别的蛋白质结构,称作表面抗原。
表面抗原有助于人体对外部病原体以及有害物质的识别和攻击。
总体而言,成熟淋巴细胞的形态特点与其免疫功能密不可分。
通过对其形态的观察,我们能够更好地了解淋巴细胞在人体免疫系统中的作用和功能。
同时,这也对于淋巴细胞相关疾病的诊治和治疗具有十分重要的意义。